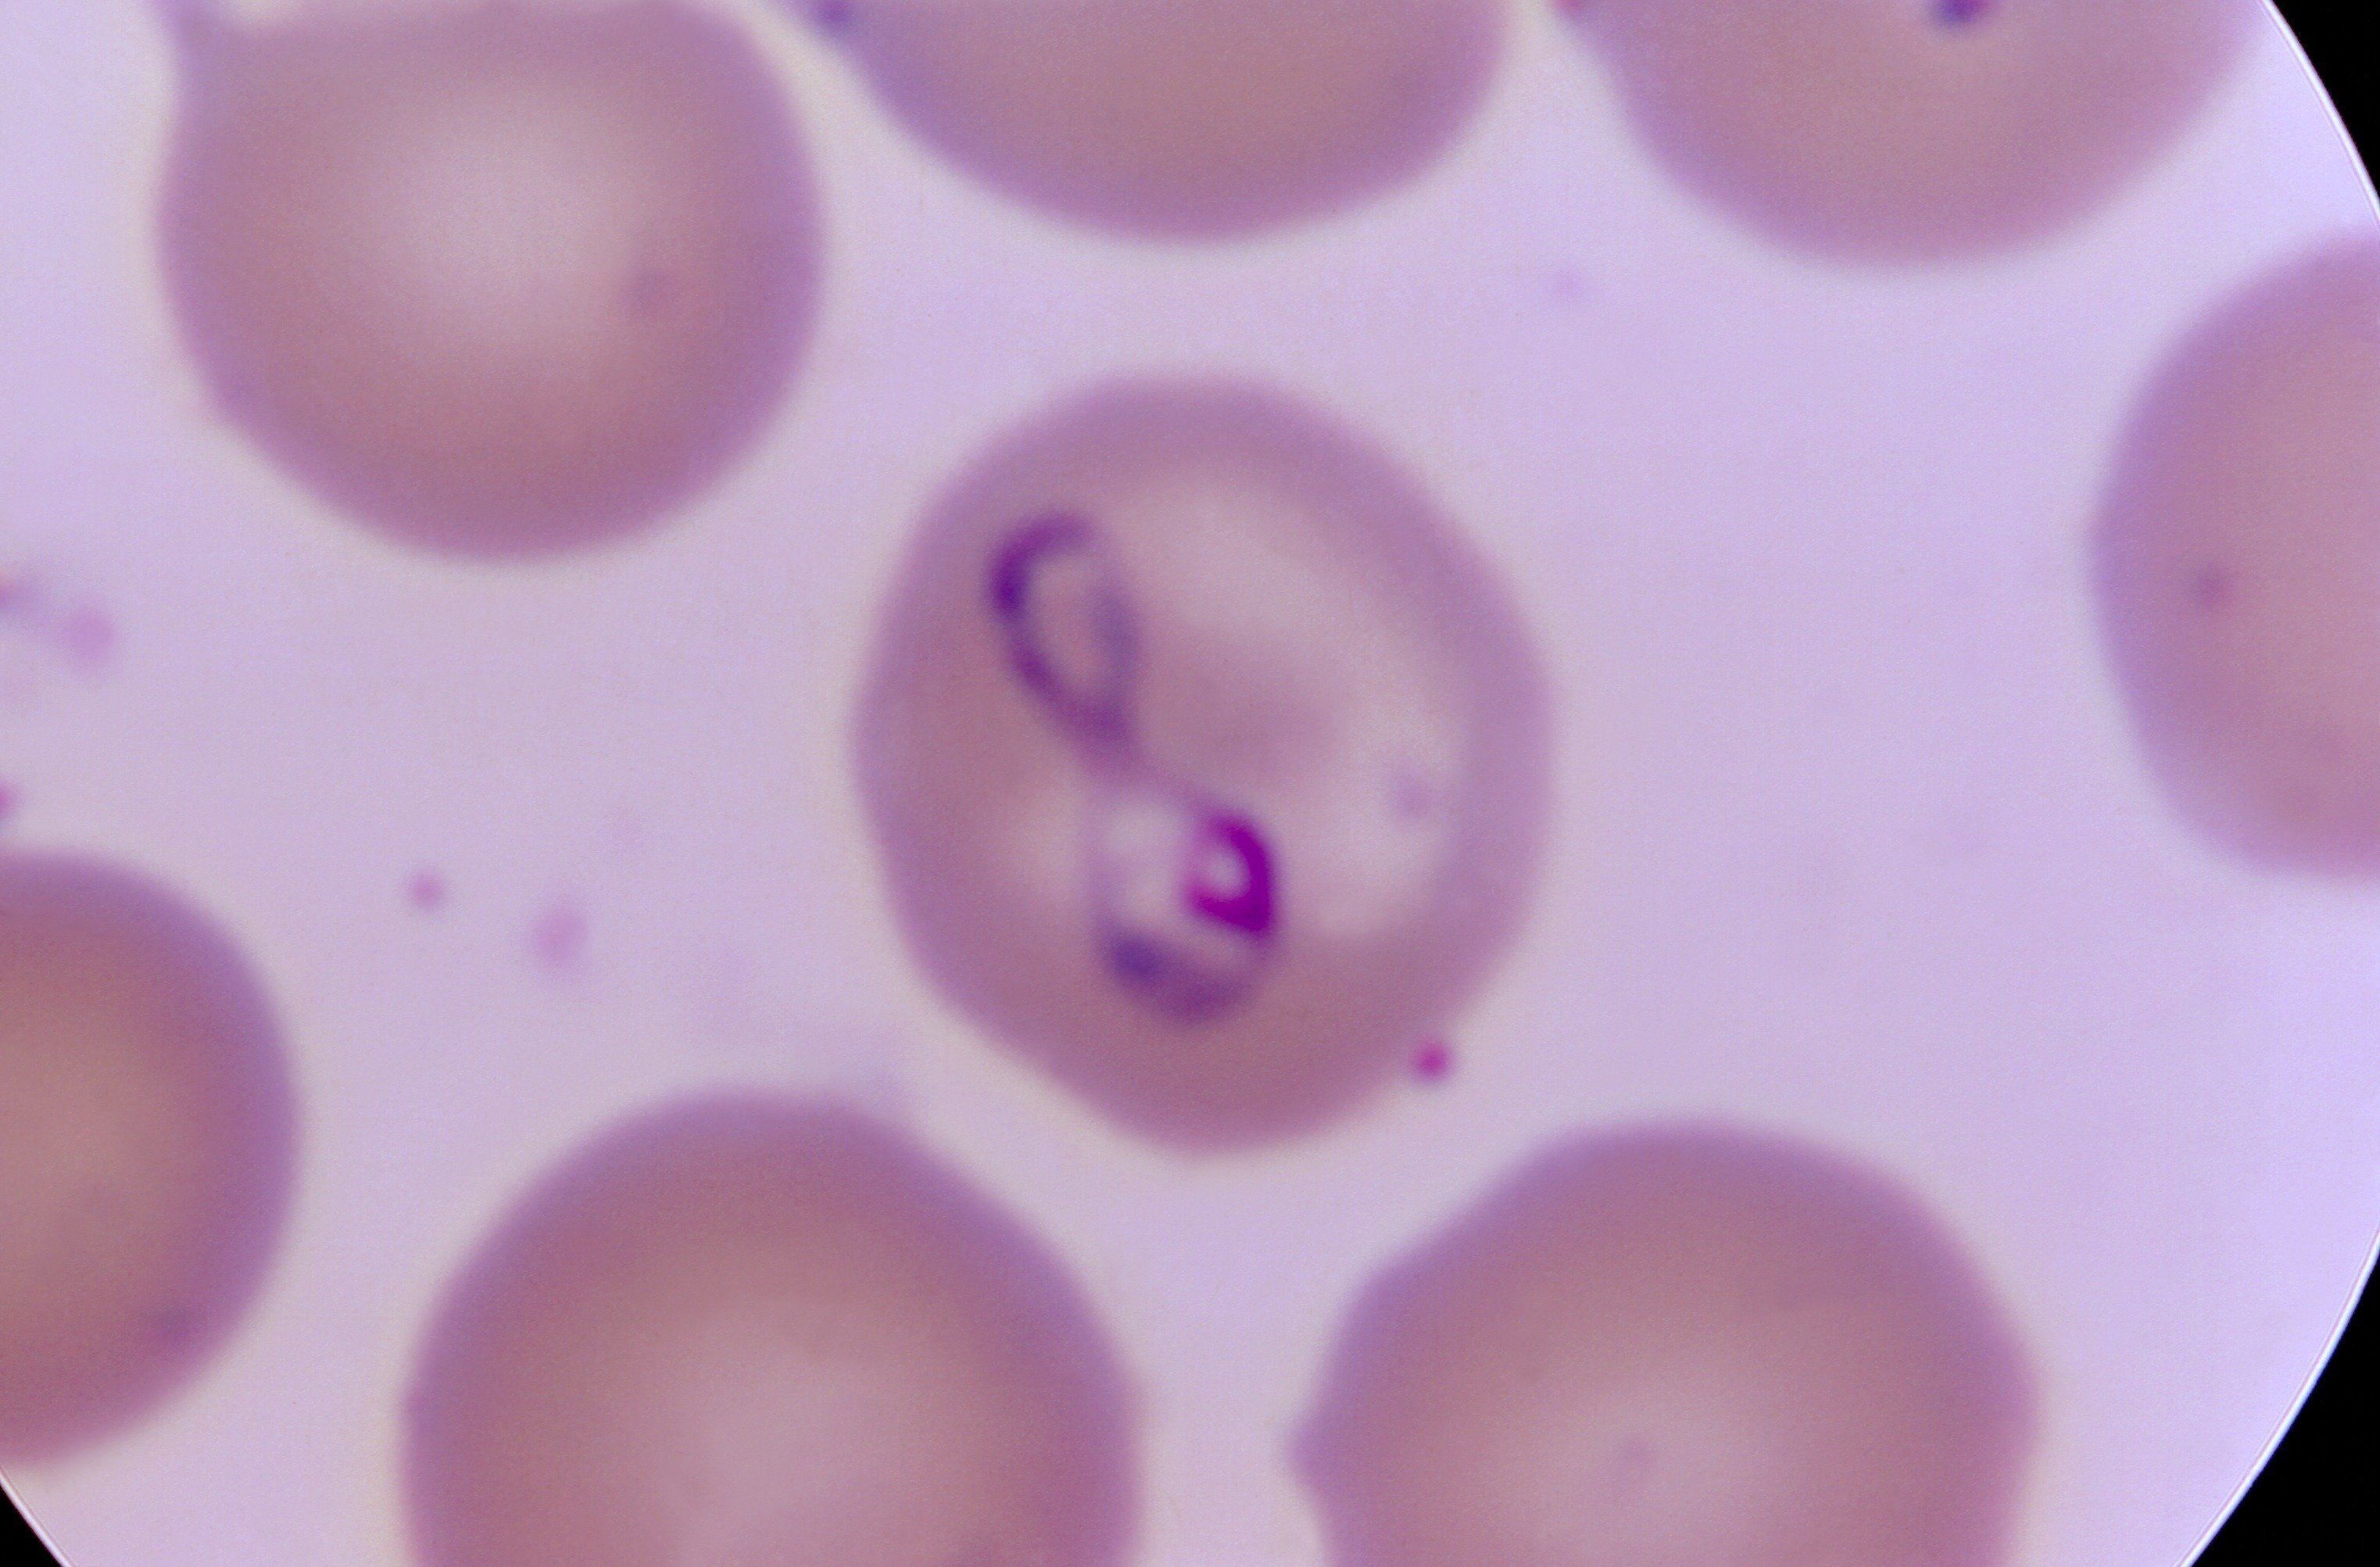
人の赤血球に寄生しているバベシアの顕微鏡写真（photo by CDC's public Health Image Library）

「たかが貧血」と思ったら大間違い
人でもよく聞く症状のため、「貧血」と聞くとなんとなく軽く考えてしまいがちですが、血液は犬の体内でたくさんの働きをしているため、場合によっては重篤な症状を招いてしまう原因になることもあるんです!「貧血」を招いてしまう、恐ろしい病気をいくつかご紹介しますので、愛犬に当てはまるものがないかすぐにチェックしてみましょう。
鉄欠乏性貧血
鉄分が不足し、体内に酸素が行き渡らなくなる
赤血球内の鉄分が不足して起こる貧血です。全身にうまく酸素が行き渡らなくなるため、疲れやすくなったり、目の粘膜が白っぽくなることもあります。血液検査によるヘモグロビンの量で診断されますが、体内に腫瘍ができていることが原因だったりすることもあるので要注意です。
溶血性貧血
何らかの原因で赤血球が破壊される
 赤血球同士がくっついてしまった状態の血(症例写真提供/東京動物医療センター)
赤血球同士がくっついてしまった状態の血(症例写真提供/東京動物医療センター)
細菌に感染したなど、何らかの原因で赤血球が破壊され、酸素が全身に行き渡らなくなります。嘔吐や呼吸困難などを伴い、重症の場合は輸血や酸素吸入などを行うことも。タマネギ中毒でも起こる症状です。
慢性腎疾患
ホルモン量が低下し、重度の貧血症状が出る
腎臓は赤血球の生産を促すホルモンを出している臓器です。そのため、慢性腎不全など、腎臓に慢性的な疾患がある場合は、重度の貧血症状を引き起こすことがあります。愛犬の体重が急に減ったり、水をたくさん飲むようになったら要注意です。
甲状腺機能低下症
体内で赤血球が作られにくくなる
甲状腺に異常が発生し、犬の体内で細胞の代謝などを行う甲状腺ホルモンの分泌が低下する病気です。全身の代謝が低下するため、赤血球の生産量が減少することから貧血症状を起こします。
アジソン病
副腎皮質からのホルモンで、血圧が維持できなくなる
副腎皮質機能低下症とも呼ばれ、副腎(腎臓の上部にある器官)から分泌されるホルモンが少なくなることで起こる病気です。コルチゾールなど、血をつくる働きをもつホルモンも減少するため、貧血症状を伴うことがあります。
バベシア症
マダニ由来の寄生虫が赤血球に寄生する
 人の赤血球に寄生しているバベシアの顕微鏡写真(photo by CDC's public Health Image Library)
人の赤血球に寄生しているバベシアの顕微鏡写真(photo by CDC's public Health Image Library)
マダニによって媒介されるバベシアという寄生虫が血液に寄生し、赤血球を破壊して貧血症状を起こします。感染後は免疫力が低下すると発症し、重症化すると内臓の機能障害を起こして死に至ることもあります。
ささいな異変でも、すぐに動物病院へ
 たかが貧血と思わずに、不安があればかかりつけ医に相談を(イラスト/須山奈津希)
たかが貧血と思わずに、不安があればかかりつけ医に相談を(イラスト/須山奈津希)
いかがでしたか? 貧血にはもしかしたら重篤な病気が隠れていることも考えられますので、「最近愛犬が元気がないな……もしかして貧血かも?」と思ったら、動物病院に相談することをおすすめします。
参考/愛犬との暮らしをもっと楽しむ『いぬのきもち』2020年4月号「犬の血液の話 まるわかりガイド」特集(監修:東京動物医療センター副院長 南直秀先生)
症例写真提供/東京動物医療センター
イラスト/須山奈津希
文/影山エマ

.jpg?w=90&h=90&resize_type=cover&resize_mode=force)
.jpg?w=90&h=90&resize_type=cover&resize_mode=force)
.jpg?w=90&h=90&resize_type=cover&resize_mode=force)

.jpg?w=90&h=90&resize_type=cover&resize_mode=force)
.jpg?w=90&h=90&resize_type=cover&resize_mode=force)

.jpg?w=90&h=90&resize_type=cover&resize_mode=force)
.jpg?w=90&h=90&resize_type=cover&resize_mode=force)
.jpg?w=90&h=90&resize_type=cover&resize_mode=force)